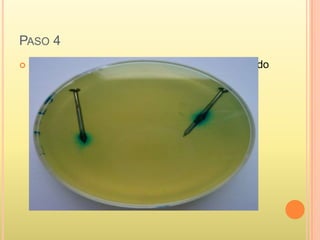
PASO 4
 Repite el mismo procedimiento anterior colocando
dentro del vaso numero 2 una fibra humedecida
con vinagre y en vaso 3 igual

Este documento trata sobre la corrosión. Explica que la corrosión es el deterioro de un material debido a un ataque electroquímico de su entorno. Describe que hay corrosión química, donde se forma una película de óxidos sobre la superficie del metal, y corrosión electroquímica, que es un proceso electromagnético. Finalmente, incluye preguntas, experimentos y crucigramas sobre los diferentes tipos y causas de la corrosión.